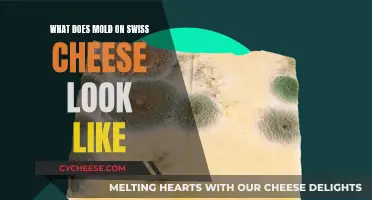
Moldy Swiss Cheese: What Does It Look Like?

Goat cheese, like all other moldy foods, should be discarded. However, some people opt to cut off the moldy parts and consume the rest of the cheese. Moldy goat cheese can be identified by its sharp or acrid smell, which is a clear sign of spoilage. The presence of mold on the surface of the cheese, which can be blue, green, grey, or cream-colored, is another indication that the cheese has gone bad. According to the USDA, some molds on goat cheese produce harmful toxins, so it is important to exercise caution when encountering moldy goat cheese.
| Characteristics | Values |
|---|---|
| Appearance | Goat cheese can accumulate mold on its surface, which can be blue, green, grey, or white. |
| Odor | Goat cheese has a distinctive "goaty" smell that is mild and musky. Moldy goat cheese may have a sharp, unpleasant, or pungent odor. |
| Texture | Moldy goat cheese may be dried out. |
| Edibility | In general, moldy cheese should be discarded as it may contain harmful toxins. However, some sources suggest that it is safe to cut off the moldy parts and consume the remaining cheese. |
Explore related products
What You'll Learn
- Goat cheese can develop a rainbow of moulds on the rind, including blue, green, grey, and cream
- The moulds on goat cheese add flavour and complexity and are usually safe to consume
- Goat cheese that has gone bad due to mould or bacteria will have a sharp or acrid smell
- Goat cheese with interior mould is undesirable and should be discarded, unlike mould on the surface, which can be cut off
- Goat cheese can be safe to consume past its best-by date, but it may become dry or develop a strong tanginess

Goat cheese can develop a rainbow of moulds on the rind, including blue, green, grey, and cream
Goat cheese can develop a variety of moulds on its rind, including blue, green, grey, and cream. These moulds are a natural part of the cheese-aging process and can add flavour and complexity to the cheese. While some people choose to cut off the mouldy parts of the cheese and consume the rest, this practice may be easier with harder cheeses, as mould can permeate soft cheeses like goat cheese more easily.
Artisanal goat's milk cheese is often left to ripen at 10 degrees Celsius, the traditional French method. At this temperature, a diverse range of microflora will develop on the rind, resulting in a variety of mould colours. These moulds are generally safe to consume if the cheese is eaten within its use-by date. However, it is important to note that some moulds can produce toxins, so it is always recommended to check the cheese for any signs of spoilage before consumption.
One key indicator of spoilage in goat cheese is a change in aroma. Fresh goat cheese should have a mild, musky, and slightly "goaty" smell. If the cheese develops a sharp, pungent, or acrid odour, it is likely past its prime or beginning to spoil. A strong ammonia smell is a clear indication that the cheese has gone bad.
Additionally, the presence of certain types of mould, such as pink or dark black-grey (Aspergillus niger) mould, indicates that the cheese should be discarded. While mould on the surface of the cheese may be safe to scrape off in some cases, interior mould is generally considered undesirable and may render the entire cheese inedible.
It is always important to exercise caution when assessing mouldy cheese. While goat cheese can develop a rainbow of moulds on its rind, it is crucial to consider factors such as smell, taste, and the type of mould present to ensure the safety and quality of the cheese before consumption.
Irish Taná Cheese: A Distinctive Taste Experience
You may want to see also

The moulds on goat cheese add flavour and complexity and are usually safe to consume
Goat's cheese is often characterised by its rind, which can vary in colour and texture depending on the moulds that form during the ripening process. When left to ripen at 10°C, the traditional French way, a variety of microflora will grow on the rind of a goat's cheese, resulting in cream, blue, green, and grey moulds. These moulds add flavour and complexity to the cheese and are generally safe to consume.
The presence of moulds on goat's cheese is not only safe but is often desired, as it contributes to the unique flavour and texture of the cheese. The specific moulds that develop can be influenced by various factors, including the original composition of the milk, the season, the weather, humidity during production and ripening, temperature, and drainage and drying techniques.
While the moulds on goat's cheese are typically safe to eat, it is important to exercise caution. If the cheese is past its use-by date or shows signs of spoilage beyond the presence of mould, it is best to discard it. Additionally, some individuals may have mould allergies or sensitivities, so consuming mouldy cheese should be approached with caution if one has any concerns or pre-existing health conditions.
The appearance of mould on goat's cheese can vary. The two most common additives to soft cheese are geotricum, a yeast that forms a cream-coloured, wrinkly rind, and penicillium candidum, a mould that creates a fluffy, velvety white coating. Goat's cheese may also exhibit blue, green, or grey moulds, which are safe to consume and contribute to the cheese's complexity.
In summary, the moulds that form on goat's cheese during the ripening process are generally safe to consume and add desirable flavour and texture profiles to the final product. However, it is important to use good judgement and avoid consuming cheese that appears spoiled or is past its use-by date.
The Unique Look of Edam Cheese
You may want to see also

Goat cheese that has gone bad due to mould or bacteria will have a sharp or acrid smell
Goat cheese, or chevre, can be challenging to assess when it has gone bad. This is because, even when fresh, goat cheese has a distinctive "goaty" aroma. However, when goat cheese has gone bad due to mould or bacteria, this smell will change from a pleasantly mild funk to something sharper and more pungent. You may even detect a nostril-searing ammonia note, which is a clear sign of spoilage.
It is important to note that mouldy goat cheese should be discarded as some moulds can produce toxins. However, this does not mean all moulds are harmful. In fact, mould is what makes cheese, cheese! The distinctive flavours and textures of different cheeses are often the result of mould, bacteria, and other microorganisms breaking down proteins and sugars in milk. That thick white rind on a wheel of Brie? That's mould! And it's perfectly safe to eat.
Artisanal goat's milk cheese, in particular, can form a variety of moulds on the rind, including cream, blue, green, and grey. When consumed within the use-by date, these moulds add flavour and complexity to the cheese and are safe to eat. However, if you notice any dark black-grey mould, this is a sign that your cheese has gone bad and should be discarded.
While mould on the surface of a cheese may be cut off and the rest of the cheese consumed, mould in the interior of the cheese is undesirable and the entire piece should be thrown away. This is because the mould has likely invaded the interior of the cheese as well, and could produce toxins that are harmful to consume.
In summary, when it comes to mouldy goat cheese, use your senses of sight and smell to assess the situation. If the mould is simply on the surface and the cheese smells fresh, you may be able to salvage it. However, if the mould has invaded the interior or the cheese has developed a sharp or acrid smell, it's best to discard it.
Mizithra Cheese: A Tasty, Traditional Greek Delicacy
You may want to see also
Explore related products

Goat cheese with interior mould is undesirable and should be discarded, unlike mould on the surface, which can be cut off
Goat cheese, or chevre, can be a tricky product to assess for freshness. Even when at its best and freshest, goat cheese has a distinctive "goaty" smell that can make it hard to know when it has gone off. Checking the best-by date is a good starting point, but it is not always reliable.
Artisanal goat's milk cheese, in particular, can form a variety of moulds on the rind, including cream, blue, green, and grey. These moulds are safe to consume and even add flavour and complexity to the cheese. However, mould on the interior of the cheese is undesirable and should be discarded.
If you discover mould on your goat cheese, it is essential to determine whether it is surface or interior mould. Surface mould can be safely cut off, and the remaining cheese can be consumed. However, if the mould has invaded the interior of the cheese, it is best to discard the entire piece.
Invisible filaments of mould can spread throughout the cheese, and some moulds can produce toxins that are harmful to consume. Trust your senses and be cautious if the cheese has changed in smell or taste. A sharp, unpleasant pungency or an acrid smell is a sign that your goat cheese has gone bad.
In summary, mould on goat cheese can be safely cut off if it is surface mould, but interior mould is undesirable and should be discarded to avoid potentially harmful toxins. Always use your best judgment and trust your senses when assessing the freshness of goat cheese.
Vaginal Odor: Why Does It Smell Like Cheese?
You may want to see also

Goat cheese can be safe to consume past its best-by date, but it may become dry or develop a strong tanginess
Goat cheese can be consumed past its best-by date, but it may not be as fresh or tasty as it once was. It is important to inspect the cheese for any signs of spoilage, as mould and bacteria can affect the taste and texture of the cheese.
Goat cheese is known for its distinctive "goaty" aroma, which should be mild and musky. If the cheese has a sharp or acrid smell, it is likely past its prime. A strong ammonia smell is a clear sign of spoilage. However, it is important to note that going bad does not always mean the cheese has become unsafe to eat; it may simply be less appealing to consume due to changes in taste or texture.
Artisanal goat's milk cheese can develop a variety of moulds on the rind, including cream, blue, green, and grey. These moulds are generally safe to consume if the cheese is eaten within its use-by date. However, if the cheese is past its best-by date, it is advisable to cut off the mouldy portions before consuming the remaining cheese. This is because mould spores can spread throughout the cheese, and some types of mould can produce toxins that are unsafe to ingest.
Goat cheese that has been vacuum-sealed or unopened is likely to remain safe for consumption, although its taste may deteriorate over time. The edges of the cheese may become dry, and the cheese may develop a stronger tanginess. If the tanginess becomes unpleasant, it is best to discard the cheese.
In summary, while goat cheese can be consumed past its best-by date, it is important to inspect the cheese for any signs of spoilage and to be aware of changes in taste and texture. Mould can be cut off and discarded, but if the cheese is heavily mouldy or has developed an unpleasant smell or taste, it is best to discard it.
Leicester Cheese: A Distinct, Nutty Flavor
You may want to see also
Frequently asked questions
Goat cheese can form a rainbow of moulds on the rind, including cream, blue, green, and grey.
It is generally advised to discard moldy goat cheese as some molds produce toxins. However, some sources suggest that it is safe to cut off the moldy parts and consume the rest of the cheese.
In addition to visible mold, a sharp or acrid smell can indicate that goat cheese has gone bad. Checking the best-by date is a good starting point, but it may not always be accurate.
Cheese is susceptible to mold due to its high moisture content, and mold growth can be influenced by factors such as storage conditions and the presence of bacteria.
Yes, according to some sources, the white mold from Brie is generally not harmful and can be safely consumed. However, it is always recommended to exercise caution when dealing with moldy cheese.